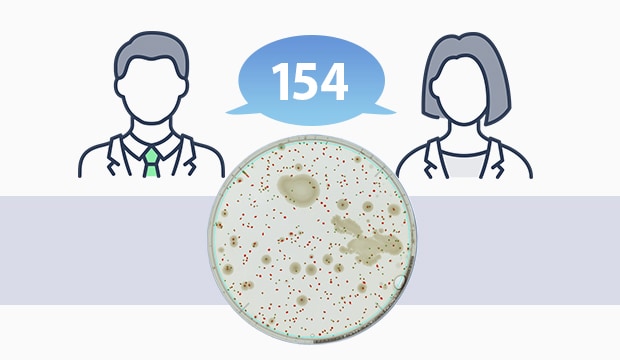

Automatischer Kolonienzähler

Der automatische Kolonienzähler der Modellreihe BC-1000 vereint eine hochauflösende Kamera mit innovativer Bildverarbeitungstechnologie und ermöglicht so eine automatische Kolonienzählung. Dies ermöglicht kürzere Zählzeiten als bei der Sichtprüfung, selbst bei einer großen Anzahl von Kolonien. Während die Ergebnisse bei Sichtprüfungen je nach Erfahrung der Anwender variieren können, ermöglicht der automatische Kolonienzähler auch unerfahrenen Anwendern zuverlässige und stabile Zählungen. Der Kolonienzähler stimmt die Bedingungen für die Bilderfassung und die Einstellungen für die Bildverarbeitung automatisch aufeinander ab, wodurch eine effizientere mikrobiolgische Prüfung erreicht wird.
Produktpalette

Zählen Sie automatisch Kolonien in nur einer Sekunde und automatisieren Sie so mikrobiologische Prüfungen. Die Kombination von KEYENCE-eigenen Objektiven, Beleuchtungs- und Bildverarbeitungstechnologien ermöglicht eine präzise Zählung selbst kleinster Kolonien mit einem hochauflösenden CMOS-Sensor mit 20 Megapixeln. Eine optimale Beleuchtungsauswahl stellt außerdem sicher, dass jede Probe für eine präzise Zählung gut sichtbar ist, und ermöglicht gleichzeitig den Ausschluss oder die Zählung von Rückständen. Die Zählergebnisse werden direkt digitalisiert, sodass eine manuelle Erfassung nicht mehr erforderlich ist und somit eine zuverlässige, digitale Verwaltung gewährleistet wird.
Merkmale
Zählung und Dokumentation auf Knopfdruck
Legen Sie einfach die Platte auf den Objekttisch, um innerhalb einer Sekunde Ergebnisse auf Knopfdruck zu erhalten. Das System verfügt über voreingestellte optimale Prüfeinstellungen für bestimmte Nährmedien und andere Faktoren, weshalb auch unerfahrene Anwender Zählungen vornehmen können.
Bisherige Methoden

BC-1000

Zuverlässige, reproduzierbare Ergebnisse für alle Anwender
Eine reproduzierbare Erkennung ist mit einer Präzision von 99% selbst bei kleinsten Kolonien möglich. Eine präzise Zählung ist sogar bei Proben möglich, die mit bisher eingesetzten Methoden nicht leicht zu zählen waren.
Kolonienzähler werden zum Zählen der Anzahl von Kolonien (Clustern), von Bakterien und anderen Mikroorganismen verwendet und werden im Allgemeinen entweder als manuelle oder automatische Zähler klassifiziert.
Manuelle Kolonienzähler werden zur Unterstützung der Sichtprüfung der Kolonien verwendet. Sie enthalten in der Regel eine Beleuchtung, um eine Petrischale mit genährten Mikroorganismen mit Durchlicht zu beleuchten, und eine Lupe, um kleinere Kolonien leichter identifizieren zu können. Einige Modelle verfügen sogar über einen eingebauten Zählstift, der bei Betätigung weitergeschaltet werden kann.
Automatische Koloniezähler hingegen verwenden eine eingebaute Kamera, um Aufnahmen von Platten zu machen und dann mithilfe von Bildverarbeitungstechnologie automatisch die Anzahl der Kolonien zu zählen. Dies ermöglicht kürzere Zählzeiten als bei der Sichtprüfung, selbst bei einer großen Anzahl von Kolonien. Während die Ergebnisse bei Sichtprüfungen je nach Erfahrung der Anwender variieren können, ermöglicht der automatische Kolonienzähler auch unerfahrenen Anwendern zuverlässige und stabile Zählungen. Der Kolonienzähler stimmt die Bedingungen für die Bilderfassung und die Einstellungen für die Bildverarbeitung automatisch aufeinander ab, wodurch eine effizientere mikrobiolgische Prüfung erreicht wird.
Vorteile von automatischen Kolonienzählern
Automatische Kolonienzähler ermöglichen die Zählung von Kolonien in viel kürzerer Zeit als bei der manuellen Zählung.
Die Zeit, die für die manuelle Zählung aufgewendet werden muss, hängt stark von der Anzahl der Kolonien ab. Mit zunehmender Anzahl steigt auch der Zeitaufwand.
Bei der manuellen Prüfung hängt die Präzision der Ergebnisse weitgehend von den Fähigkeiten des Anwenders ab, von dem die Prüfung durchgeführt wird. Zudem können die Ergebnisse selbst bei derselben Kolonie zwischen dem Prüfpersonal variieren. Die visuelle Zählung von Kolonien ist eine arbeitsintensive und zeitaufwendige Aufgabe. Die Ergebnisse können aufgrund unterschiedlicher Fähigkeiten und Ermüdung des Prüfpersonals variieren.
Automatische Kolonienzähler stellen sicher, dass die Zählungen unter den gleichen Bedingungen durchgeführt werden können, was eine präzise Zählung ermöglicht.
Bei der Verwendung eines automatischen Kolonienzählers liegen die Ergebnisse direkt in digitalisierter Form vor. Diese Daten können dann in eine Zähltabelle oder eine andere Software exportiert werden, um sie nicht nur für Aufzeichnungen, sondern auch für eine Vielzahl von Analysen zu verwenden, wie zum Beispiel produkt- oder standortbezogene Trendanalysen.
Die Digitalisierung der Aufnahmen und Ergebnisse verhindert das Auftreten von Datenmanipulationen und ermöglicht die Aufzeichnung von Betriebsprotokollen (Audit Trails), wodurch die Einhaltung von 21 CFR Part 11 und anderen Richtlinien erleichtert wird.
Das Zählen der Kolonien mit einem automatischen Kolonienzähler erfolgt in zwei Schritten: Erstellung einer Aufnahme und automatische Auszählung der Kolonien. Um bei jedem Schritt die besten Ergebnisse zu erzielen, müssen verschiedene Anforderungen erfüllt werden.
Bilderfassung
Neben der Pixelanzahl, die häufig mit dem Thema Aufnahmequalität in Verbindung gebracht wird, spielen weitere Faktoren eine wichtige Rolle. Nachfolgend werden weitere Punkte vorgestellt, die einen großen Einfluss auf die Aufnahme und Zählung haben.
Ist die Performance des Objektivs gut genug, um eine verzerrungsfreie Aufnahme der Petrischale zu erhalten?
Wenn die Aufnahme der Kolonien Verzerrungen in den Randbereichen hat, kann dies die Zählung beeinträchtigen. Außerdem hängt die Auflösung der Aufnahme von der Kamera- und Objektivauflösung ab. Nur wenn beide eine gleichermaßen gute Performance und Auflösung haben führt dies zu einer geeigneten Aufnahme für die Zählung.
Wird die gesamte Petrischale gleichmäßig ausgeleuchtet?
Eine ungleichmäßige Beleuchtung kann zu Unterschieden in der Sichtbarkeit von Kolonien an verschiedenen Positionen führen, was sich negativ auf die Zählergebnisse auswirken kann. Eine Änderung der Platzierung der Petrischale kann auch das Aussehen der Probe verändern, was zu Herausforderungen wie unterschiedlichen Ergebnissen führt, selbst wenn dieselbe Probe gezählt wird. Ein System, welches eine gleichmäßige Ausleuchtung über die Petrischale gewährleistet, ermöglicht es reproduzierbare Prüfungen durchzuführen.
Kann die Beleuchtung für eine Vielzahl von Bakterien und Nährmedien verwendet werden?
Bei einigen Bakterienarten und Nährmedien kann es am besten sein, die Petrischale von oben zu beleuchten (Epi-Beleuchtung), während es sich bei anderen empfiehlt, die Probe von unten zu beleuchten (Durchlichtbeleuchtung). Darüber hinaus müssen einige Proben möglicherweise mit diffusem und gedämpftem Licht anstatt mit direkter Beleuchtung aufgenommen werden. Ein System mit einem flexiblen Beleuchtungssystem, das verschiedene Bedingungen bietet, macht es einfacher, die beste Aufnahme für die automatische Zählung zu erhalten.
Wie einfach ist die Einstellung der Bedingungen für die Bilderfassung?
Bei mikrobiologischen Prüfungen geht es häufig um die Zählung einer Vielzahl von Kolonien auf Basis eines Produktionsplans. Wenn es notwendig ist, die Lichtverhältnisse für jede Prüfung anzupassen, wird die Effektivität der automatischen Zählung erheblich reduziert. Wenn Sie sicherstellen, dass die Einstellungen einfach konfiguriert werden können und die Bedingungen bei Bedarf reproduzierbar sind, können Sie die Effizienz des Betriebs verbessern.
Bildverarbeitung (Einstellungen der Zählbedingungen)
Kolonien gibt es in vielen verschiedenen Formen und Größen, und bei der Sichtprüfung werden die Ergebnisse von der Erfahrung und dem Können des Prüfpersonals beeinflusst. Bei der automatischen Zählung hingegen werden die verschiedenen Kolonien nach Farbinformationen (Farbton, Sättigung, Helligkeit usw.) und Forminformationen (Fläche, Rundheit usw.) in Parameter zerlegt. Anschließend werden für jeden Parameter Schwellenwerte festgelegt, um die Zählobjekte zu bestimmen. Die individuelle Einstellung von allen diesen Parameter ist kompliziert und zeitaufwändig. Aus betrieblicher Sicht ist es daher am besten, eine benutzerfreundliche Bedienoberfläche zu haben, die es dem Anwender ermöglicht, so viele Einstellungen wie möglich automatisch zu konfigurieren.
Häufig gestellte Fragen zu automatischen Kolonienzählern
Die Modellreihe BC-1000 von KEYENCE kann nicht nur mit Petrischalen, sondern auch mit Zählplatten und Wellplates verwendet werden. Darüber hinaus sind Halterungen für eine Vielzahl anderer Behälter verfügbar.
Die Modellreihe BC-1000 umfasst verschiedene Funktionen wie Benutzerverwaltung und Audit Trails, die die Einhaltung von 21 CFR Part 11 ermöglichen.
Neben der Einhaltung von 21 CFR Part 11 sind auch normkonforme Zählmethoden für weitere Normen möglich: FDA BAM, AOAC 977.27, GB 4789.2, GB 7918.2, ISO 7218, ISO 4833.2 und ISO 15189.
Datenintegrität (DI) bezieht sich auf Daten, die vollständig, konsistent und präzise sind. Mit anderen Worten: Die Datenintegrität steht für die Zuverlässigkeit der Daten.
Dies ist eine grundlegende Anforderung der Guten Herstellungspraxis (engl. Good Manufacturing Practice, abgekürzt GMP; Pharmaceutical Manufacturing Control & Qualitätskontrollstandards), einem Konzept der pharmazeutischen Industrie, das die Hersteller einhalten müssen.
Die Datenintegrität ist eine Voraussetzung für alle Arten von Aufzeichnungsmedien, und unabhängig von der Aufzeichnungsmethode (Papier, digital usw.) müssen entsprechende Maßnahmen getroffen werden.

![Schnelle Lieferung nach Bestellung? Abwicklung in nur zwei Tagen. [Jetzt informieren] Ganz egal ob Komponenten-Upgrade, Ersatzbeschaffung oder Neugerät!](/Images/QuickDelivery-300x300_2047143.png)